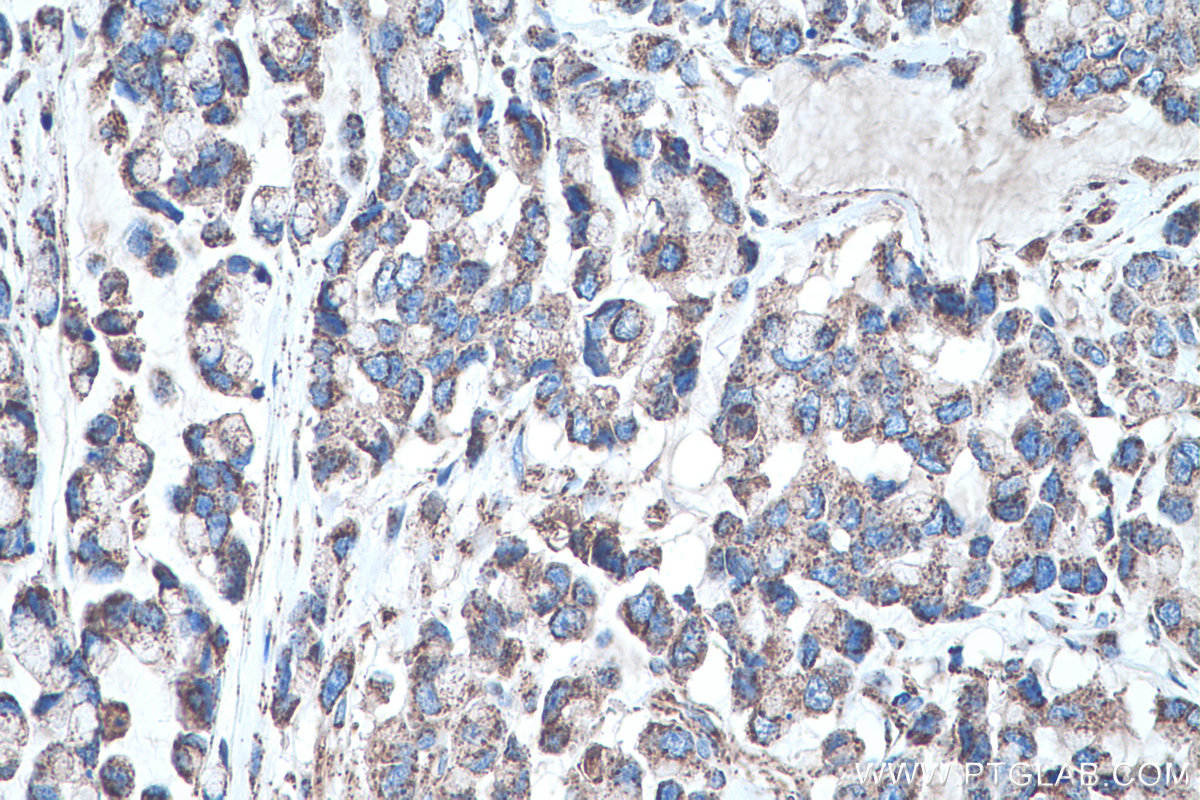

验证数据展示
经过测试的应用
| Positive WB detected in | U2OS cells, HeLa cells, ROS1728 cells, RAW 264.7 cells, pig brain tissue, rat brain tissue, mouse brain tissue |
| Positive IHC detected in | human liver cancer tissue, human liver tissue, human colon cancer tissue, human pancreas cancer tissue, mouse liver tissue, rat liver tissue Note: suggested antigen retrieval with TE buffer pH 9.0; (*) Alternatively, antigen retrieval may be performed with citrate buffer pH 6.0 |
| Positive IF/ICC detected in | HUVEC cells |
| Positive FC (Intra) detected in | HeLa cells |
推荐稀释比
| 应用 | 推荐稀释比 |
|---|---|
| Western Blot (WB) | WB : 1:5000-1:50000 |
| Immunohistochemistry (IHC) | IHC : 1:2500-1:10000 |
| Immunofluorescence (IF)/ICC | IF/ICC : 1:200-1:800 |
| Flow Cytometry (FC) (INTRA) | FC (INTRA) : 0.40 ug per 10^6 cells in a 100 µl suspension |
| It is recommended that this reagent should be titrated in each testing system to obtain optimal results. | |
| Sample-dependent, Check data in validation data gallery. | |
产品信息
66474-1-Ig targets SOD2 in WB, IHC, IF/ICC, FC (Intra), CoIP, ELISA applications and shows reactivity with human, mouse, rat, pig samples.
| 经测试应用 | WB, IHC, IF/ICC, FC (Intra), ELISA Application Description |
| 文献引用应用 | WB, IHC, IF, CoIP |
| 经测试反应性 | human, mouse, rat, pig |
| 文献引用反应性 | human, mouse, rat, pig, goat |
| 免疫原 |
CatNo: Ag21388 Product name: Recombinant human SOD2 protein Source: e coli.-derived, PET28a Tag: 6*His Domain: 1-140 aa of BC016934 Sequence: MLSRAVCGTSRQLAPALGYLGSRQKHSLPDLPYDYGALEPHINAQIMQLHHSKHHAAYVNNLNVTEEKYQEALAKGRFQAERREAVPGRGDPREPGPIRTGLSVEENSLRICTGSEFSRHDSLSFKHMVYLIVEGVPRWV 种属同源性预测 |
| 宿主/亚型 | Mouse / IgG2a |
| 抗体类别 | Monoclonal |
| 产品类型 | Antibody |
| 全称 | superoxide dismutase 2, mitochondrial |
| 别名 | SODM, 3A6C2, EC:1.15.1.1, IPO B, IPOB |
| 计算分子量 | 25 kDa |
| 观测分子量 | 25 kDa |
| GenBank蛋白编号 | BC016934 |
| 基因名称 | SOD2 |
| Gene ID (NCBI) | 6648 |
| RRID | AB_2881840 |
| 偶联类型 | Unconjugated |
| 形式 | Liquid |
| 纯化方式 | Protein A purification |
| UNIPROT ID | P04179 |
| 储存缓冲液 | PBS with 0.02% sodium azide and 50% glycerol, pH 7.3. |
| 储存条件 | Store at -20°C. Stable for one year after shipment. Aliquoting is unnecessary for -20oC storage. |
背景介绍
SOD2(superoxide dismutase 2, mitochondrial ) is also named as IPOB, MNSOD, SODM, Mn-SOD and belongs to the iron/manganese superoxide dismutase family. It is a marker of mitochondria, which is restricted to the perinuclear area in a cell with aggregate formation of mutant SOD1(PMID:12659845). It functions as the first line of antioxidant defense against highly reactive superoxide radicals and it appears to be early predictors for survival in septic patients with with MIF(PMID:20863520). It has 2 isoforms with the molecular weight of 25 kDa and 21 kDa.
实验方案
| Product Specific Protocols | |
|---|---|
| FC protocol for SOD2 antibody 66474-1-Ig | Download protocol |
| IF protocol for SOD2 antibody 66474-1-Ig | Download protocol |
| IHC protocol for SOD2 antibody 66474-1-Ig | Download protocol |
| WB protocol for SOD2 antibody 66474-1-Ig | Download protocol |
| Standard Protocols | |
|---|---|
| Click here to view our Standard Protocols |
发表文章
| Species | Application | Title |
|---|---|---|
Adv Sci (Weinh) Mitochondrial tRNAGlu 14693A>G Mutation, an "Enhancer" to the Phenotypic Expression of Leber's Hereditary Optic Neuropathy | ||
Int J Biol Macromol Ultra-small platinum nano-enzymatic spray with ROS scavenging and anti-inflammatory properties for photoaging treatment | ||
J Control Release A cerium oxide loaded glycol chitosan nano-system for the treatment of dry eye disease. | ||
Stem Cell Res Ther Apoptotic vesicles resist oxidative damage in noise-induced hearing loss through activation of FOXO3a-SOD2 pathway | ||
Oxid Med Cell Longev HO-1 Contributes to Luteolin-Triggered Ferroptosis in Clear Cell Renal Cell Carcinoma via Increasing the Labile Iron Pool and Promoting Lipid Peroxidation. | ||
Mol Ther Nucleic Acids Diverging targets mediate the pathological roleof miR-199a-5p and miR-199a-3p by promoting cardiac hypertrophy and fibrosis |